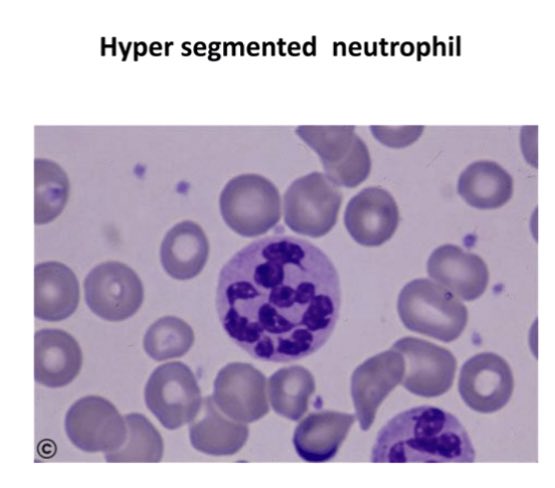
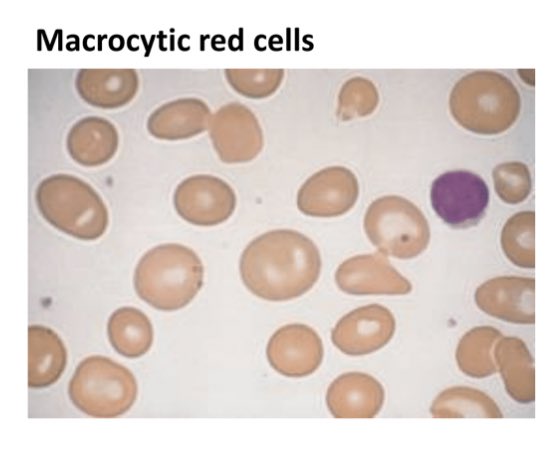

موضوع رقم 6️⃣بسلسلة الانيميا😻
macrocytic anemiaيعني خلايا الدم كبيره بالجحم
فيه منها نوعين :
١-megaloblastic
يميزها وجود الhypersegmented neutrophil
يكون سببها نقص بال:
*folate ⬇️
*B12⬇️
وهي موضوعنا اليوم
macrocytic anemiaيعني خلايا الدم كبيره بالجحم
فيه منها نوعين :
١-megaloblastic
يميزها وجود الhypersegmented neutrophil
يكون سببها نقص بال:
*folate ⬇️
*B12⬇️
وهي موضوعنا اليوم
٢-non-megaloblastic
مافي وجود لل hypersegmented neutrophil❌
يكون سببها :
١-امراض الكبد
٢-بعض الادويه
٣-الحكول وغيرها
مافي وجود لل hypersegmented neutrophil❌
يكون سببها :
١-امراض الكبد
٢-بعض الادويه
٣-الحكول وغيرها
نتلكم عن النوع الاول megaloblastic
خلونا نعرفها ونعرف ايش سببها/✔️
تعريفها : عباره عن مشكله بالDNA synthesis
زي ما احنا عارفين الخلايا وهي غيرناضجه تكون كبيره بالحجم ولما تنضج تصغر بالحجم وكله بفضل ال DNA synthesis الموجود جوا النواه ترسل اشارات هو يسويلي هذه العمليه
خلونا نعرفها ونعرف ايش سببها/✔️
تعريفها : عباره عن مشكله بالDNA synthesis
زي ما احنا عارفين الخلايا وهي غيرناضجه تكون كبيره بالحجم ولما تنضج تصغر بالحجم وكله بفضل ال DNA synthesis الموجود جوا النواه ترسل اشارات هو يسويلي هذه العمليه
لكن بهذه الانيميا انا اساساً عندي مشكله بـ
DNA synthesis الي جوا النواه فماراح ترسل اشارات ويضل حجمها كبير ومايصغر
طيب هل بس الRBC راح تكون كبيره كذا؟ لا كل الخلايا
DNA synthesis الي جوا النواه فماراح ترسل اشارات ويضل حجمها كبير ومايصغر
طيب هل بس الRBC راح تكون كبيره كذا؟ لا كل الخلايا
كمان فيه شيء ثاني يصير اسمه ineffective erythropoiesis
ليش؟لان الجهاز المناعي متعود على خلايا صغيره فلما يشوف هذه الخلايا الكبيره يحسبها غريبه ويقوم يهاجمها عن طريق الماكروفاج
مو بس الRBCزي ماقلنا كمان يهاجم الWBCوالPltلانها كمان تكون كبيره بالحجم
فهذا الشي يعطينيpancytopenia⬇️
ليش؟لان الجهاز المناعي متعود على خلايا صغيره فلما يشوف هذه الخلايا الكبيره يحسبها غريبه ويقوم يهاجمها عن طريق الماكروفاج
مو بس الRBCزي ماقلنا كمان يهاجم الWBCوالPltلانها كمان تكون كبيره بالحجم
فهذا الشي يعطينيpancytopenia⬇️
lab findinig📈:
1-CBC
*⬇️Hb
*⬇️HCT
*⬆️اكبر من 100 MCV
لان حجمها كبير
*⬇️pancytopenia
1-CBC
*⬇️Hb
*⬇️HCT
*⬆️اكبر من 100 MCV
لان حجمها كبير
*⬇️pancytopenia
جاري تحميل الاقتراحات...